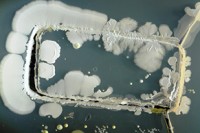

Auch gefährliche Keime keine Seltenheit
Bakterien auf Smartphone Displays
Auf den Displays unserer Smartphones tummelt sich ein bunter Bakterien-Cocktail. Neben zumeist harmlosen Keimen haben Forscher darunter auch Spuren von Fäkalien, Krankheitserreger und sogar Überträger tödlicher Krankheiten gefunden …
Weiterlesen
